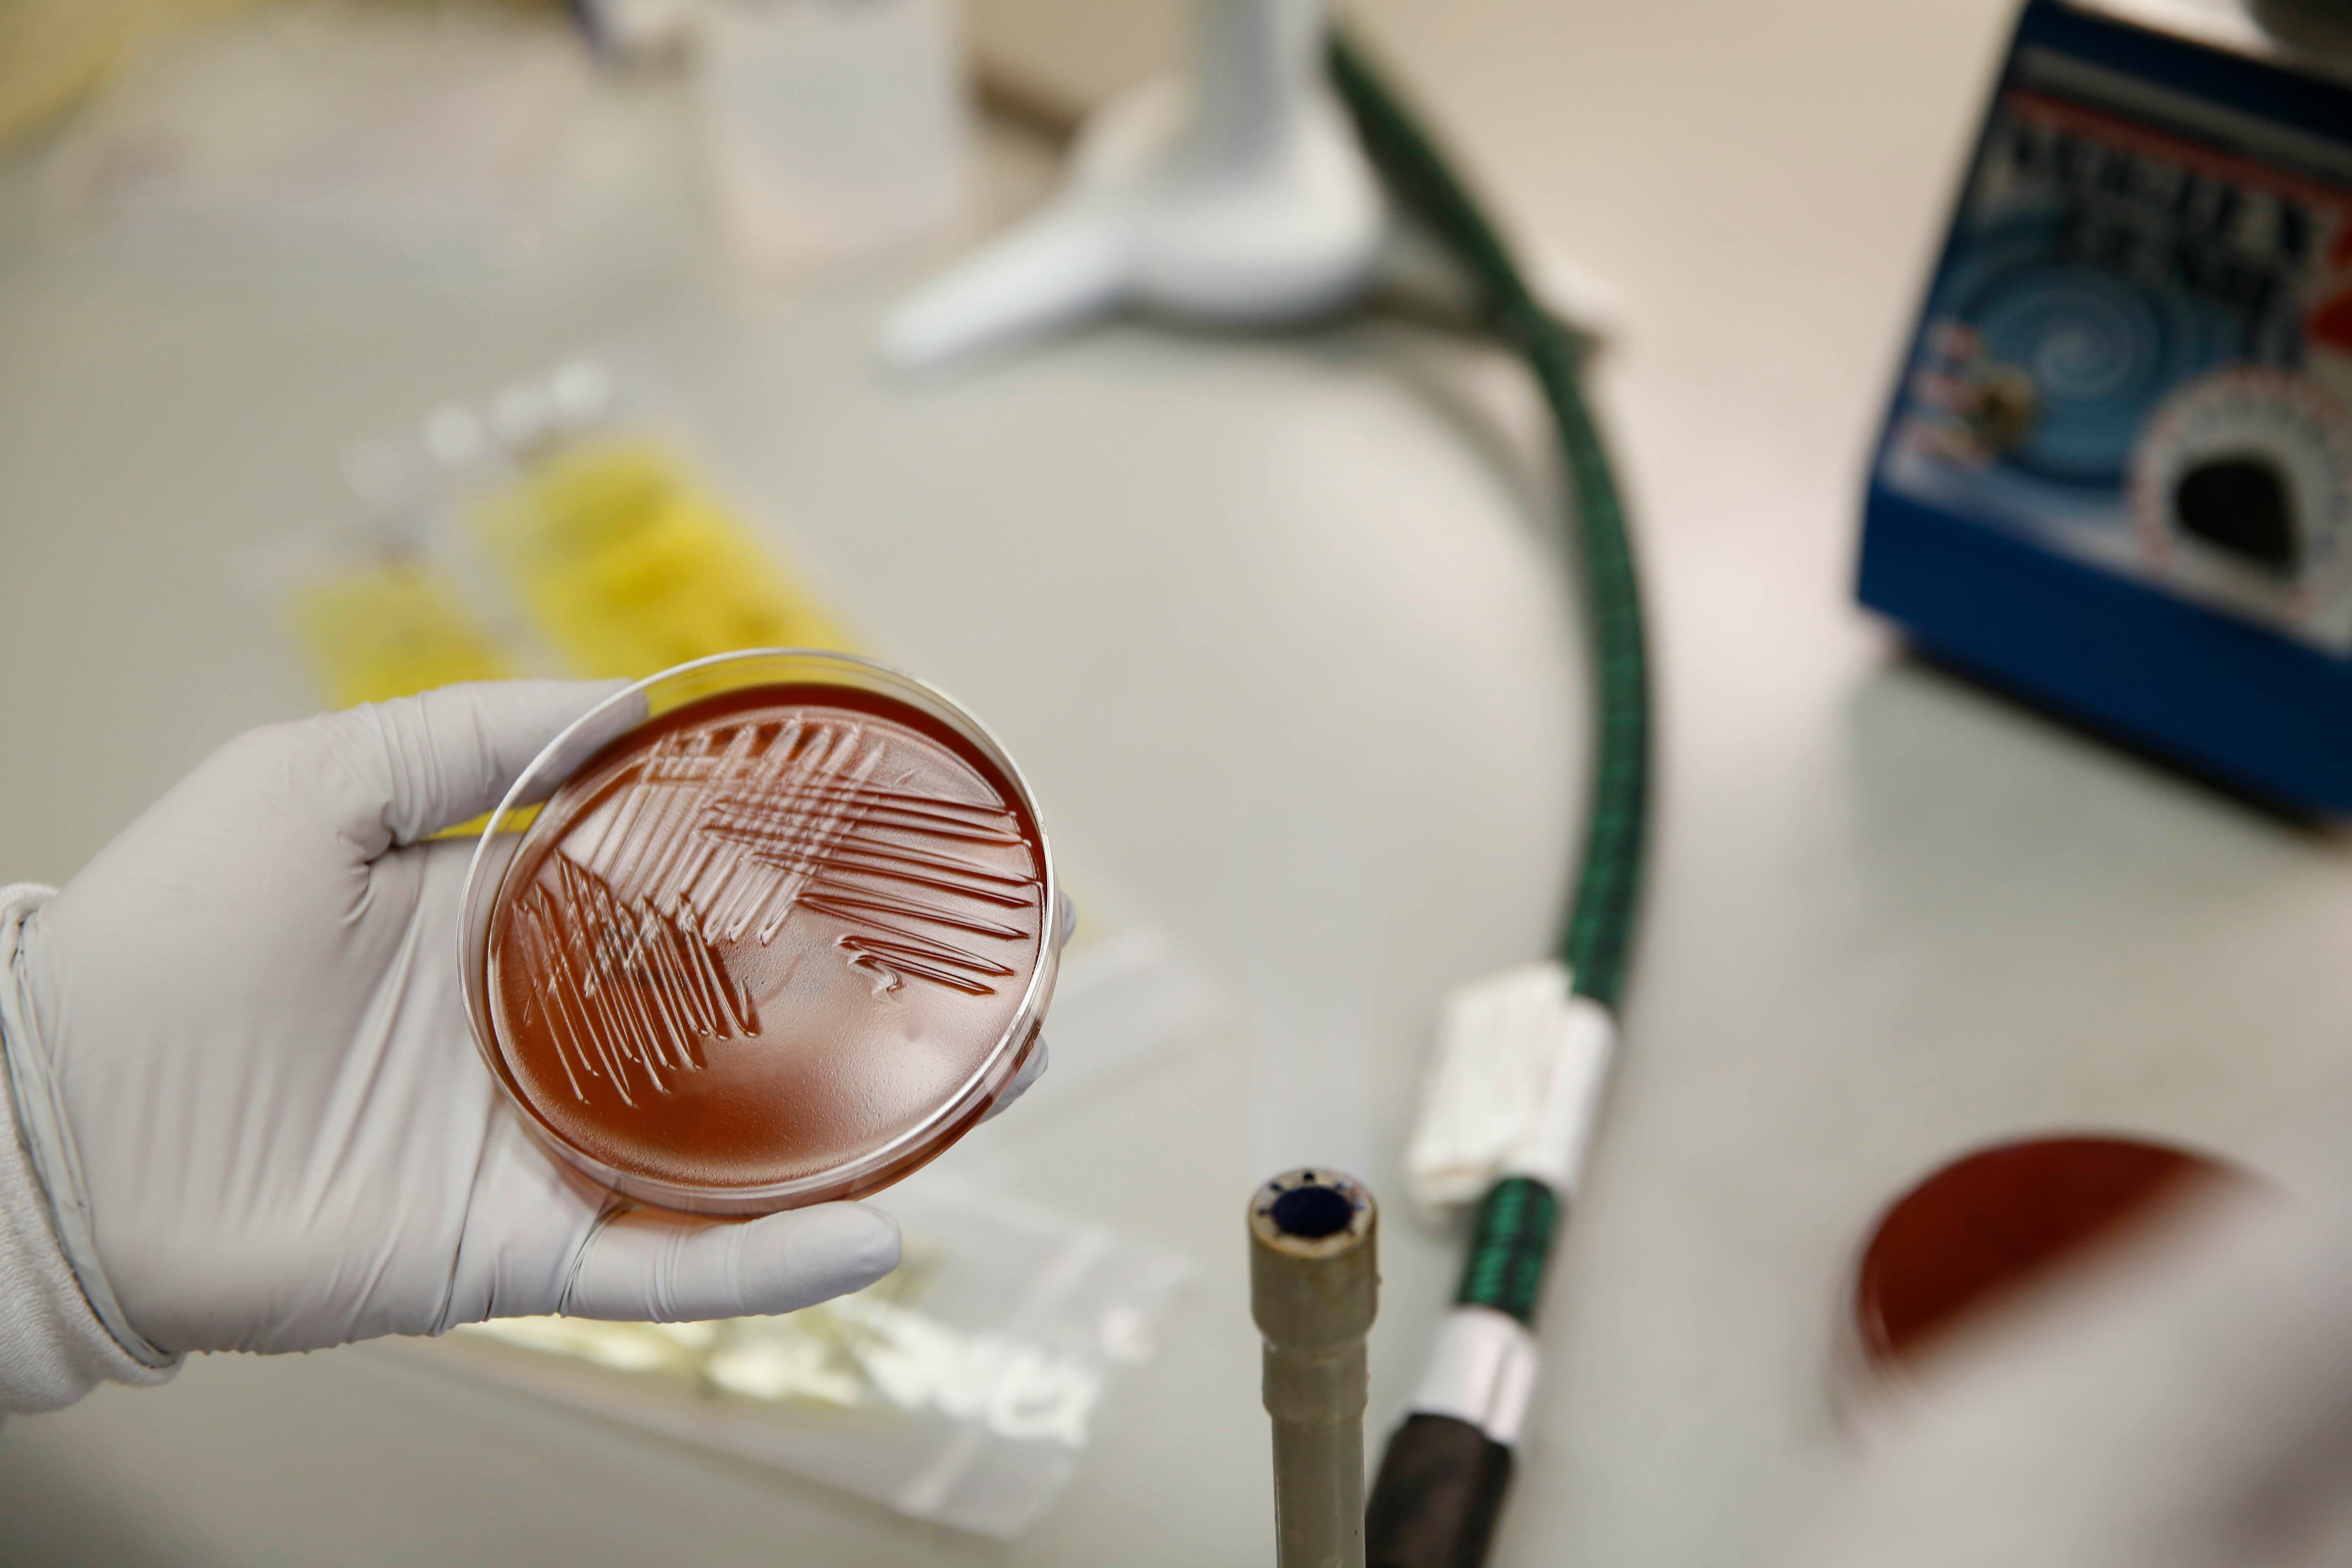

In your digestive system are trillions of microorganisms. These bacteria, viruses, and fungi are collectively known as the microbiome.
Scientists are increasingly aware of the microbiome’s critical role in influencing physical and mental health. Now they’ve come across a specific function of gut health: The microbiome may affect your ability to lose weight.
The bacterial cells in the gastrointestinal tract contain genes — together these outnumber the host’s genes by more than 100 times. In a new study, scientists found your likelihood of losing weight when you’re actively trying to, whether it be through diet or exercise, is influenced by the genes and enzymes within the bacteria living in your gut.
These findings were published September 14 in the journal mSystems.
LONGEVITY HACKS is a regular series from Inverse on the science-backed strategies to live better, healthier, and longer without medicine. Get more in our Hacks index.
Lead author Christian Diener is a research scientist at the Institute for Systems Biology. He tells Inverse weight-loss-resistant microbiomes are likely a result of “lifestyle and environmental factors.”
“Westernized diets seem to have a tendency to move the microbiome in a direction that facilitates gaining weight,” Diener says.
The food we eat plays an essential role in overall health. Fiber-friendly foods — like broccoli and apples — and food rich in resistant starch — like potatoes and legumes — are a good place to start.
Science in action — While it’s known lean and obese people often display differences in their gut flora, this study reveals fresh insight: There are different sets of genes encoded in gut bacteria that respond differently to weight-loss interventions.
The researchers analyzed data collected on participants in a lifestyle intervention program who agreed to share their blood and stool samples. They also filled out dietary questionnaires.
In this case, the intervention didn’t have to do with exercise or food. Instead, participants took part in a commercial behavioral coaching program and received advice from a nurse and a dietician.
From this group, the study team focused on:
- Forty-eight people who lost more than one percent of their body weight per month over a six to 12 month period
- Fifty-seven people who did not lose any weight and maintained a stable body mass index (BMI) over a six to 12 month period
Subsequent analysis revealed three key findings:
- Different genes encoded in gut bacteria were associated with weight-loss responses, including stress-response genes, respiration-related genes, cell wall synthesis genes, and polysaccharide and protein degradation genes.
- Genes that help bacteria replicate and grow faster were found more often in the samples belonging to people who lost more weight.
- People who did not lose weight had gut microbiomes that break down starches at a quicker rate.
How this affects longevity — It’s increasingly understood that good gut health is key to overall good health. This study expands that understanding to weight loss, finding gut microbiota influence weight-loss outcomes.
Critically, the gut microbiota isn’t the only factor that influences weight: The study authors emphasize that there are a number of confounding variables, including age, physical activity, and overall health.
But this is a variable we didn’t really understand before now — and it offers a new opportunity for understanding why some efforts to lose weight work for some and not for others.
Being overweight, however, doesn’t necessarily mean you are unhealthy. It’s a gray area: Obesity can put some at risk for health conditions like diabetes and stroke, others can be overweight but still, be healthy people. These individuals are categorized by scientists as “metabolically healthy obese.”
This study has more to do with people who want to lose weight but are struggling to do so despite participating in the same interventions. Gut microbiota and associated genes influenced their overall success rate — suggesting to the study authors that there are mechanisms that can explain variation in some weight loss.
Why it’s a hack — This study suggests that in the future probiotics could be used as weight-loss tools. But take this with a pinch of salt. Diener describes this potential as a “maybe,” adding “we still have a bit to go.”
For example, some studies suggest individuals with high Prevotell copri, a common human gut microbe, lose more weight if they follow a high-fiber diet. Diener and colleagues also observed the bacteria growing faster in the study participants who lost more weight.
“However, whether a Prevotella copri probiotic would indeed work everybody still needs to be shown,” he says. “Just eating Prevotella if you have low abundances is unlikely to work since another bacterial genus in the gut, Bacteroides, usually compares with Prevotella and will shut it out from colonizing a high Bacteroides gut microbiome.”
“The most effective pre-and probiotic interventions of the future will likely need to be personalized to each individual’s gut ecosystem,” Diener adds. Whether or not a probiotic helps depends on the “ecological context” of the person swallowing them down.
This is why eating a healthy and diverse diet, including a variety of unprocessed plant-based carbohydrates and fibers is “probably more effective for now,” he says.

While there is no silver bullet, changing diet can alter the composition of the gut microbiome. On a broad scale, the study team four that most of the genes associated with resistance to weight loss were involved in breaking down complex sugar molecules into simple ones. Because of this, Diener reasons that “enriching the diet in complex carbohydrates” — like dietary fibers and unprocessed foods — could help change the microbiome “into one that delivers less simple sugars back to us.”
He also points to the work of Rachel Carmody, an assistant professor at Harvard University, who found transplanting the microbiomes of mice fed on starches to mice who were not fed on starches caused the latter group to gain more weight.
While more research — especially including a larger study sample who track what they eat — is needed, these findings do reinforce the idea that our gut microbiomes adapt to our bodies and lifestyle. And because microbiota extract nutrients from diets, what you eat becomes an actionable way to maintain health
The key to healthy weight loss may be less about limiting what you put in your stomach and more about eating foods that give your gut a helping hand.
Hack score — 🥔 🍠 🍠 🍎 🍎 (5/10 foods rich in fiber and resistant starch)